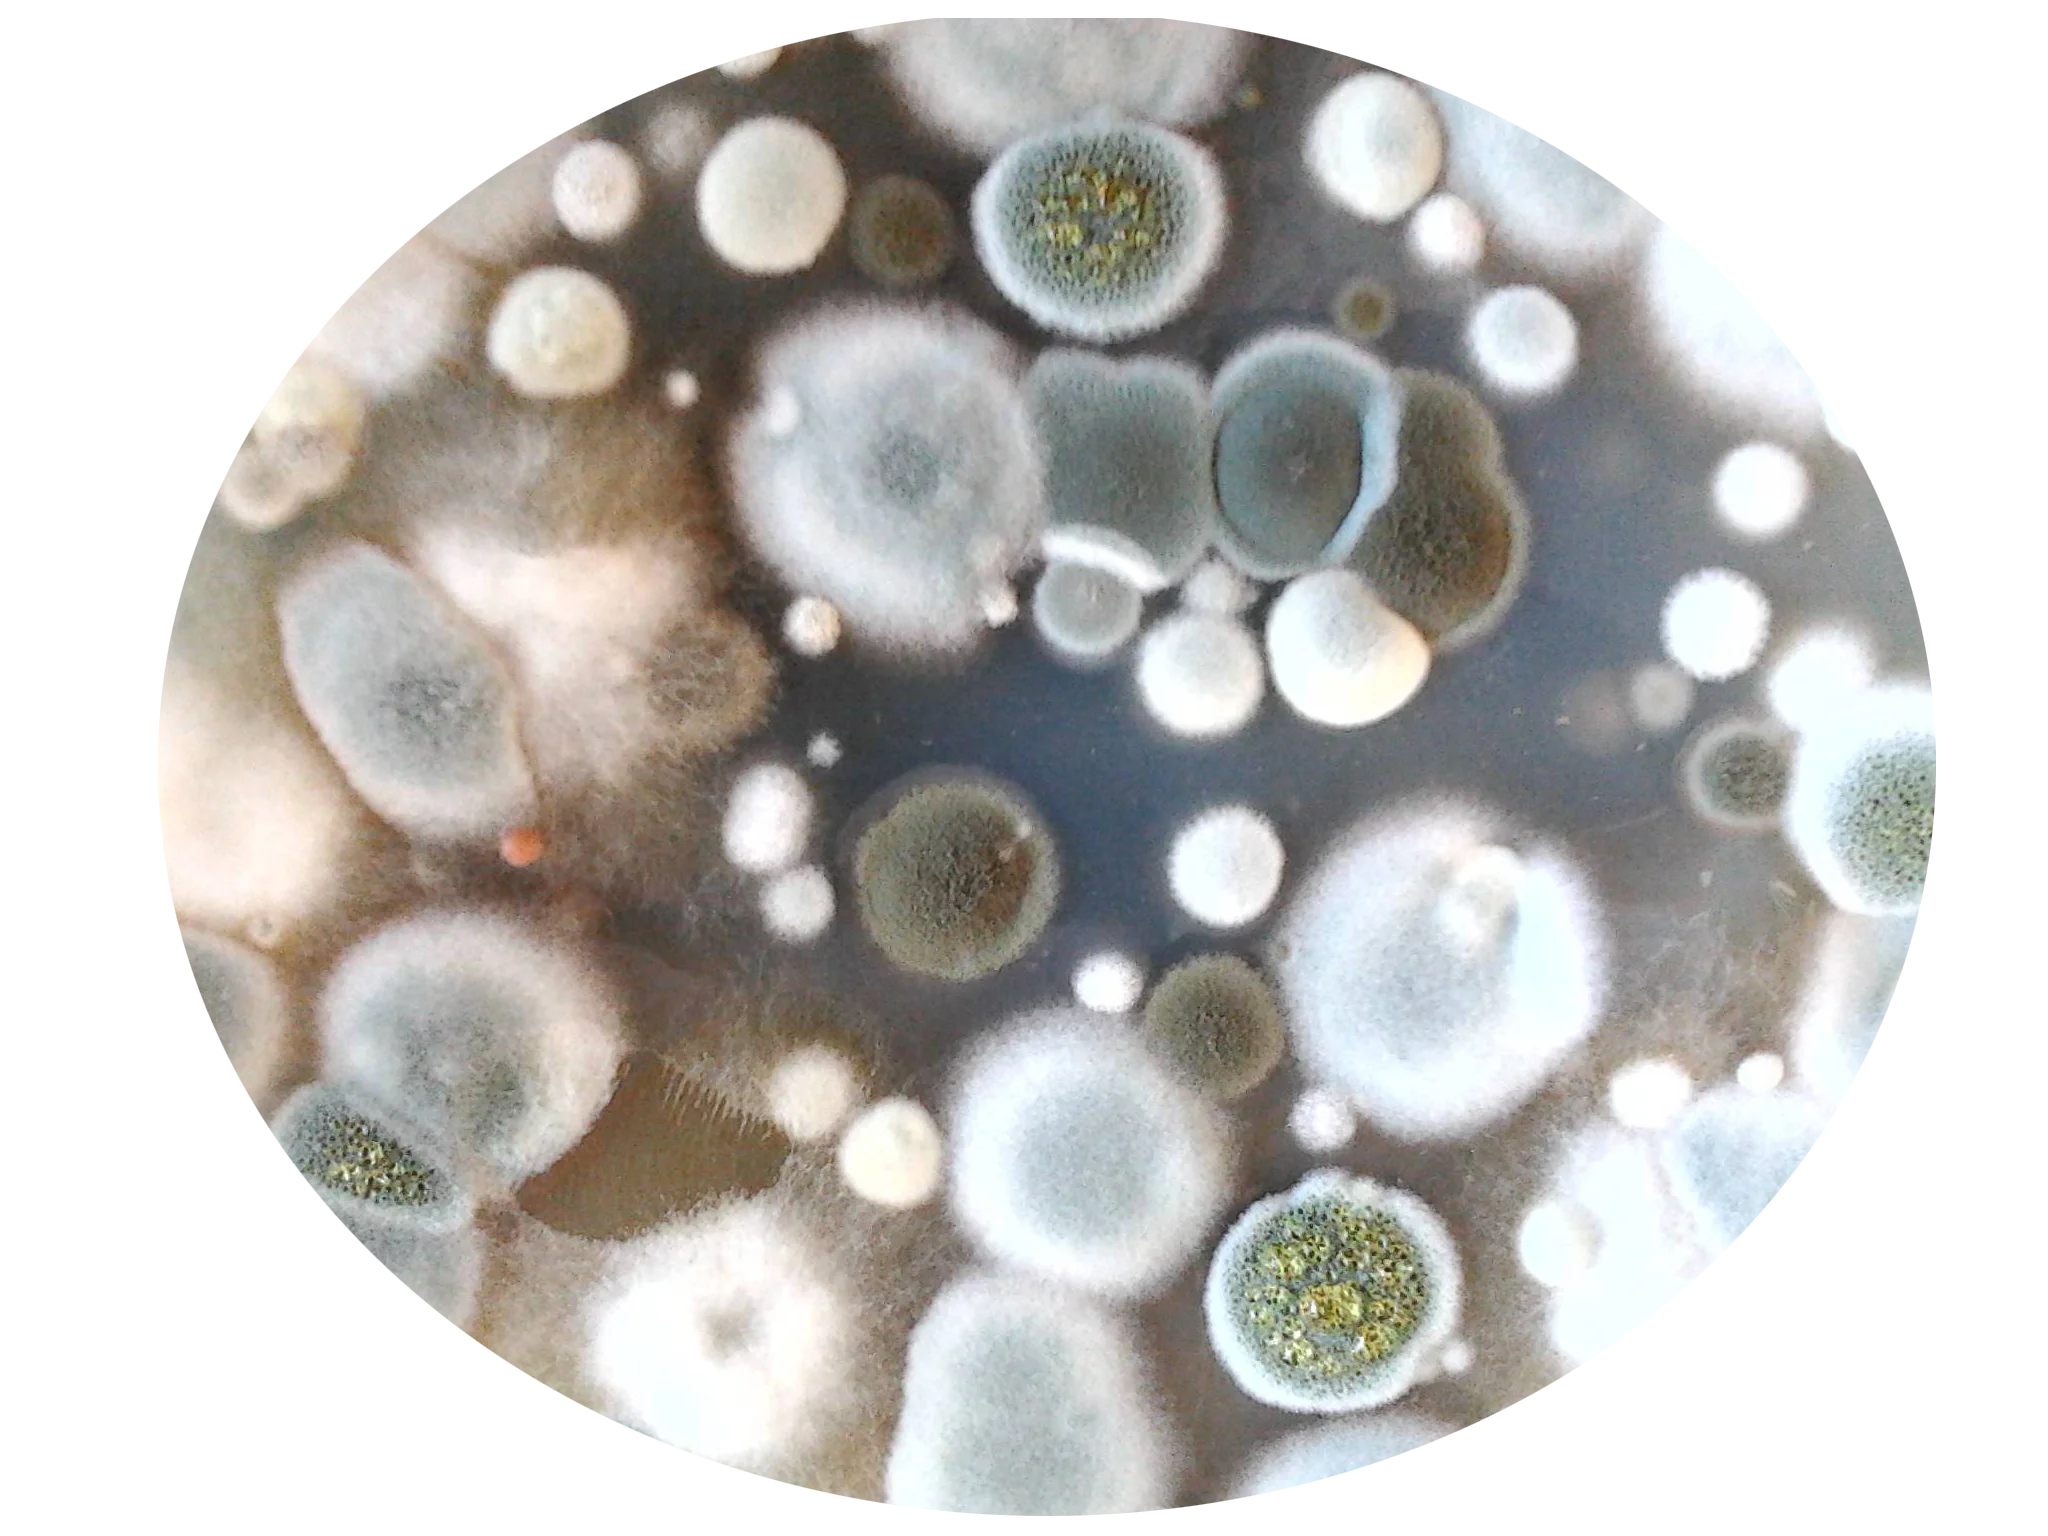
.png

Моногидрат лимонной кислоты Colorcom лимонная кислота
US $1.00-$1.70
Поделиться:
Insen Factory Wholesale Bulk Myo-Inositol Myo Inositolr


| Product name: | Bulk Inositol Powder |
| CAS NO.: | 87-89-8 |
| Molecular Formula: | C6H12O6 |
| Purity: | 98% |



Food Industry |  |
 | Feed Industry Inositol is used for culture of various strains and promotion yeast growth.As a feed additives, not only increase growth rate, but also avoid the most common inositol deficiency of shrimpand fish. |
| Fermentation Industry Inositol is used for culture of various strains and promotion yeast growth | |
 | Health Products Industry |










